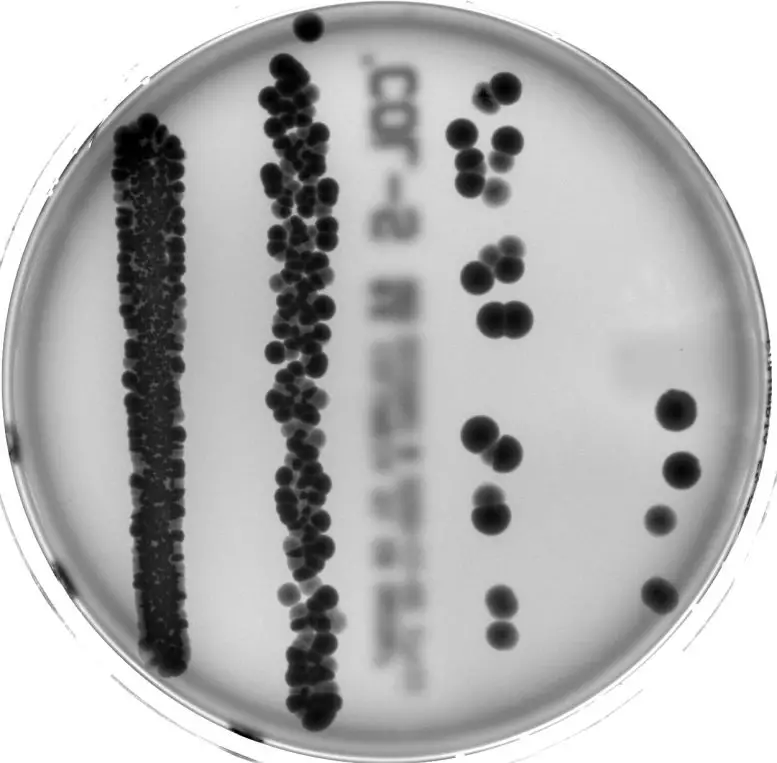

新研究显示,微生物群为细胞分裂提供了重要的构建模块。当器官的一部分被切除时,身体有能力再生缺失的肝脏组织。然而,慕尼黑工业大学(TUM)的研究人员最近发现,这一过程的效力在很大程度上受到肠道细菌的影响。这些发现有可能提高患有肝癌和其他疾病的人的肝脏手术效果。
人类的肝脏具有惊人的再生能力,与心脏等不同。潜在的生物机制是我们的肠道细菌在其他器官发生的过程中发挥作用的一个例子。来自慕尼黑大学伊萨尔河畔医院(Klinikum rechts der Isar)和慕尼黑大学生命科学学院的一个跨学科团队进行的新研究证明了这一点。
一个健康的肠道微生物群由多种类型的细菌组成。它们在消化过程中发挥着积极作用。例如,它们中的一些将碳水化合物分解为短链脂肪酸(SCFAs)。研究负责人、伊萨尔河畔医院(Klinikum rechts der Isar)外科的克劳斯-彼得-扬森(Klaus-Peter Janssen)教授说:"肝细胞需要这些脂肪酸来生长和分裂。我们现在首次成功地证明,肠道细菌影响了肝细胞的脂质代谢,从而影响了它们的再生能力。"
杨森教授和他的团队在小鼠身上进行了实验,以确定被破坏的微生物组如何影响肝脏再生。在通过抗生素扰乱微生物组的动物中,新肝细胞的形成被强烈推迟。科学家们已经意识到了抗生素和肝脏再生中断之间的联系。然而,这以前被归因于身体的免疫反应或抗生素对肝细胞的有害副作用。
与肠道细菌的机理联系在TUM的研究中才得以显现。与用抗生素治疗的小鼠相比,出生时就缺乏微生物组的小鼠的肝细胞也没有再生。
"微生物群启动组"激活了肝细胞的生长
"抗生素并不能杀死所有的肠道细菌,"该研究的两位第一作者之一Anna Sichler解释说。"然而,药物治疗改变了微生物组的组成:剩下的细菌种类产生的短链脂肪酸要少得多"。微生物群通常在抗生素治疗的几周内恢复。目前的研究表明,在用抗生素治疗的动物中也发生了肝脏再生,但有一个明显的延迟。在缺乏肠道细菌的小鼠中,没有发生再生。然而,研究人员能够通过用精确定义的"微生物组启动组"治疗它们来刺激肝脏再生。
用器官和人类细胞进行的实验
使用由小鼠细胞组成的器官--基本上是在培养皿中的微型肝脏--研究人员证明,SCFAs为肝细胞的细胞膜提供了必要的构建模块。如果SCFAs的数量不足,细胞就会拒绝生长和繁殖。当细胞因为有足够的脂肪酸而繁殖时,研究小组发现,一种被称为SCD1的酶特别活跃。
"我们随后用人类肝脏细胞和组织样本调查了这些过程,"Yuhan Yin说,"当肝脏再生时,SCD1在人类中也很活跃"。他也是该研究的第一作者。
"重要的是要记住,肠道细菌在我们体内的作用是非常复杂的。"克劳斯-彼得-扬森说:"在我们完全了解它之前,我们还有很长的路要走。因此,这项研究并没有为进一步的行动或药物开发提供具体建议。"然而,我们的结果可以用于新的研究,即哪些微生物组的组成能够为肝脏再生提供更好的条件"。
然后,医生可以检查病人的肠道细菌,以确定条件是否有利于手术,或是否最好等待微生物组的恢复",也许还可以通过某种饮食来影响恢复。
而反过来,医生也可能通过粪便样本检查微生物组,以确定手术后肝脏的再生情况,这个问题将是该团队进一步研究的主题。